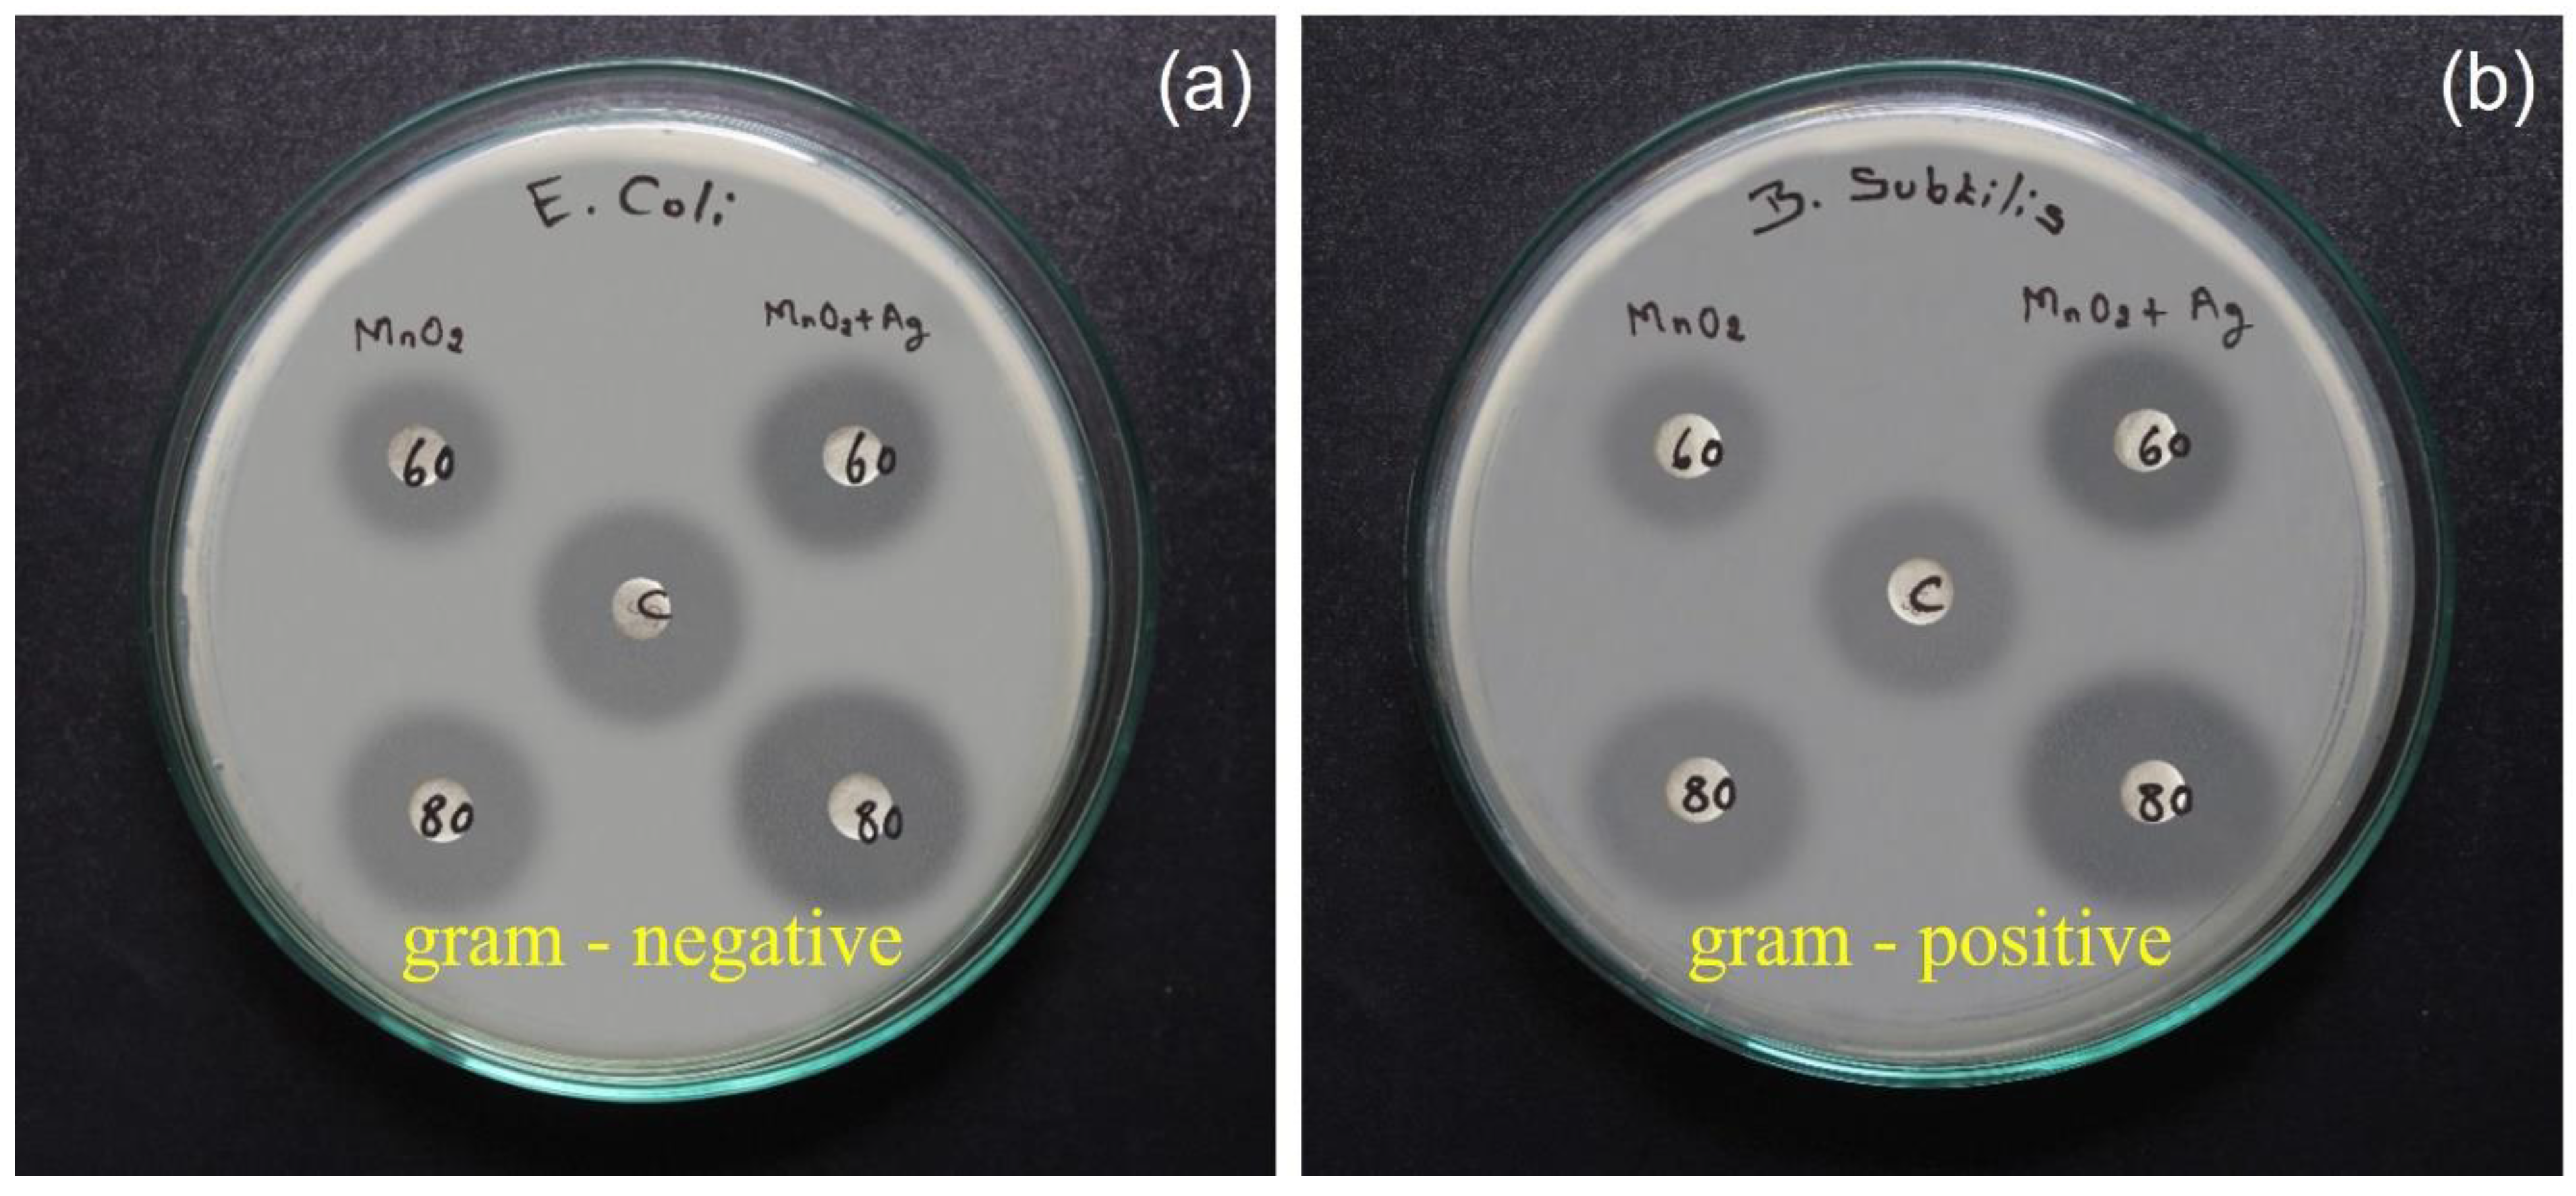
Catalysts 13 00397 g010
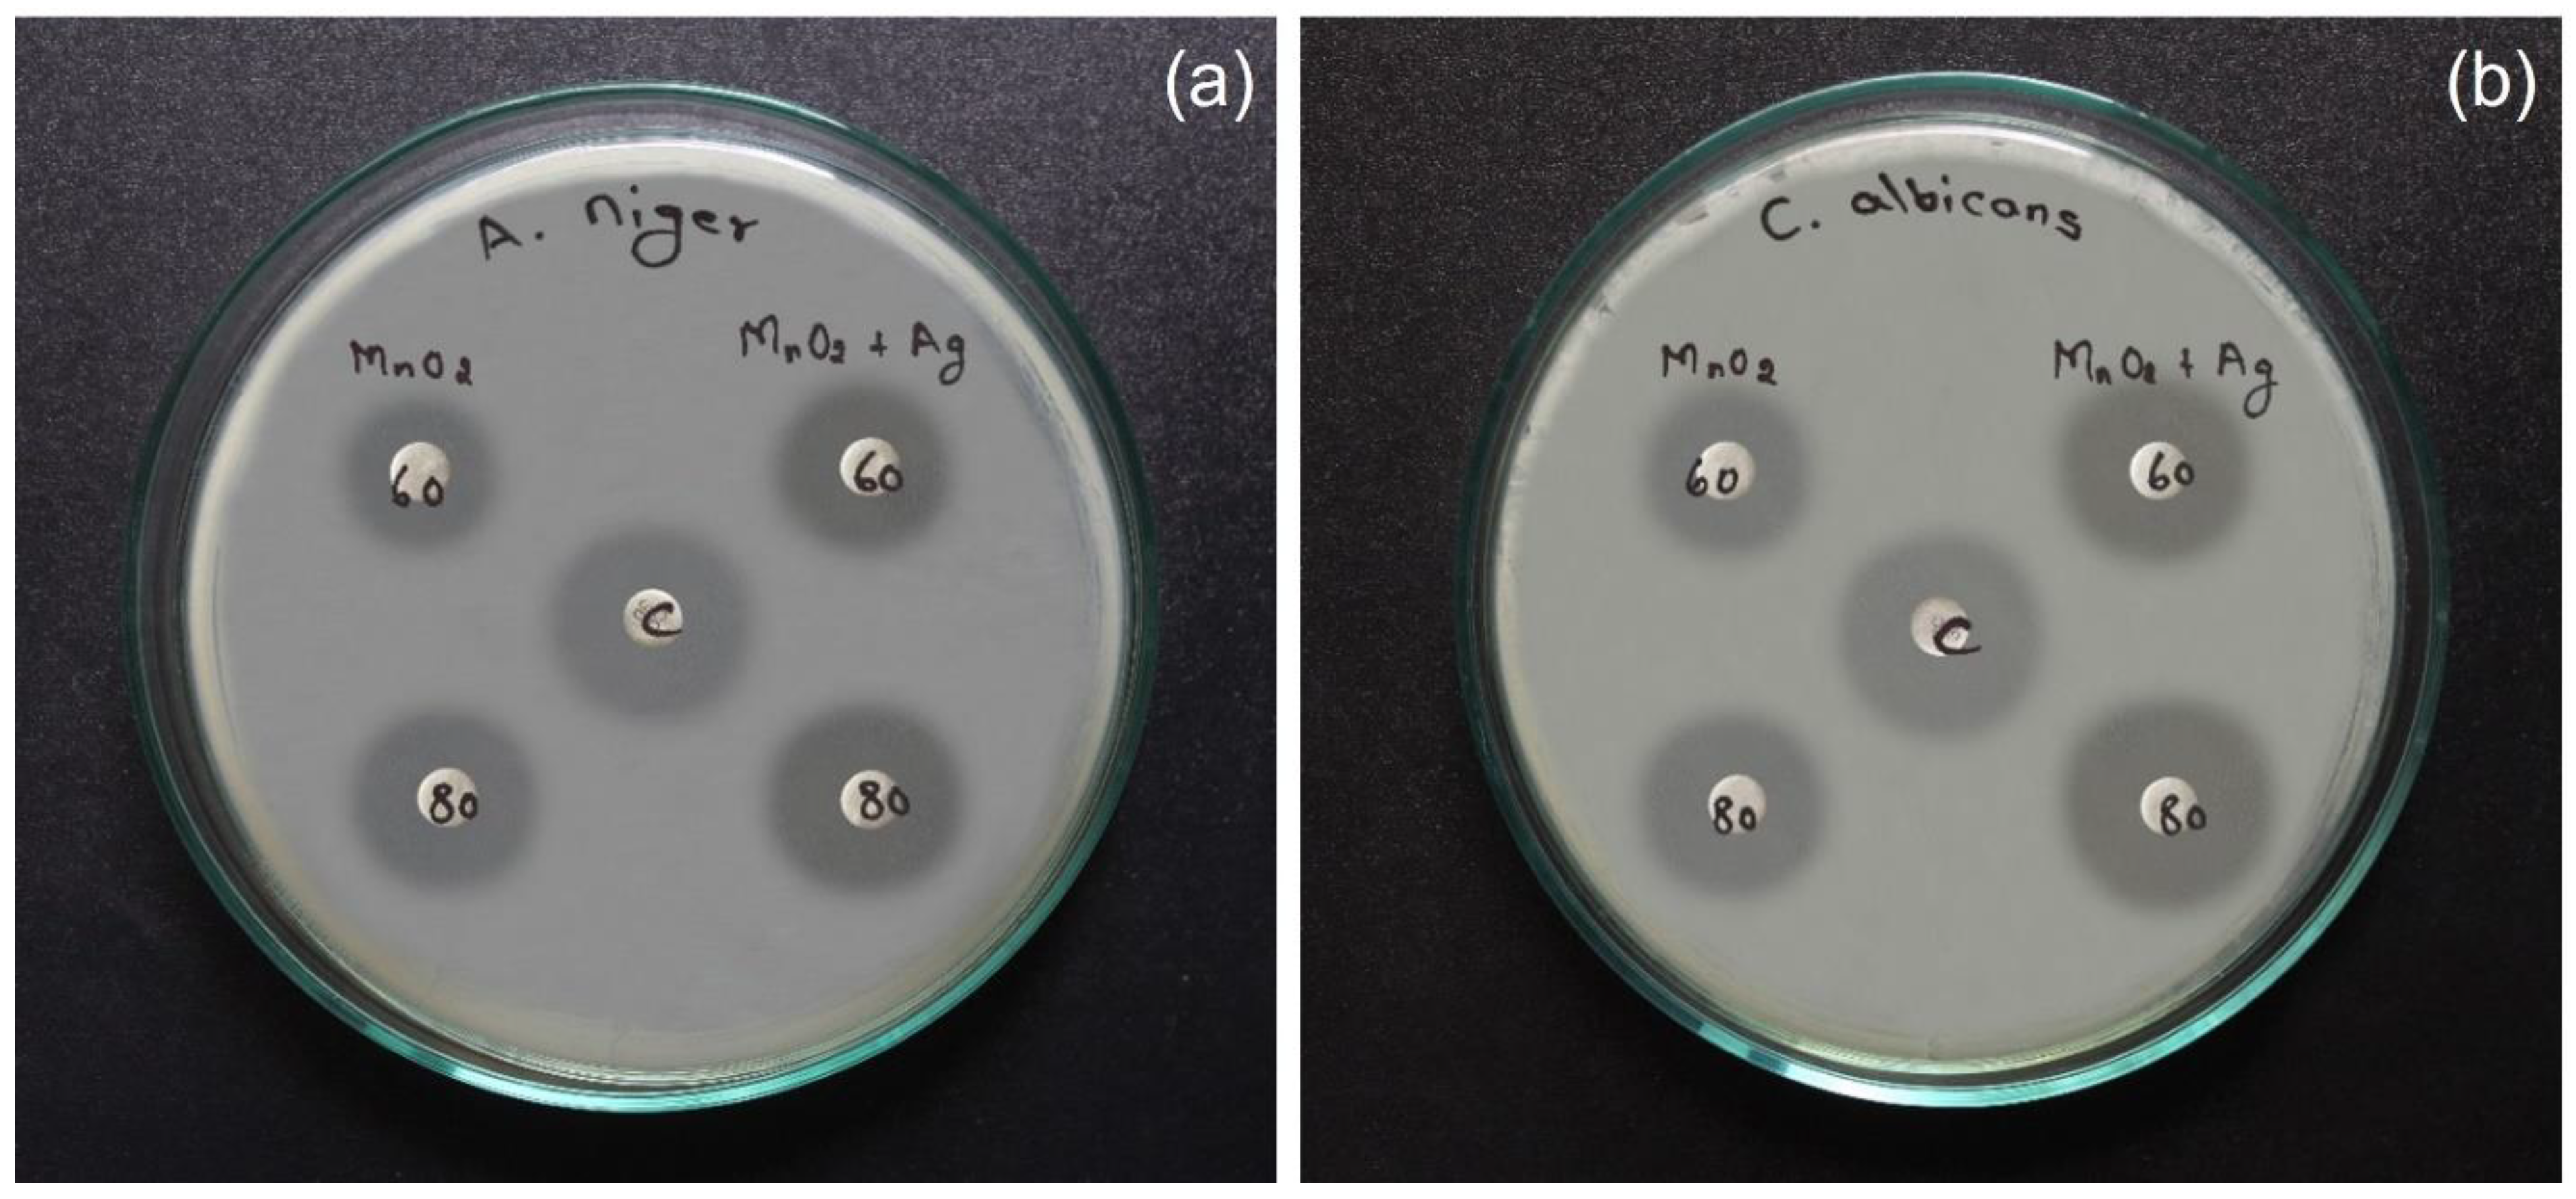
Catalysts 13 00397 g012

MnO2 Doped with Ag Nanoparticles and Their Applications in Antimicrobial and Photocatalytic Reactions
Abstract
:1. Introduction
2. Results and Discussion
2.1. XRD Analysis
2.2. UV Absorbance Analysis
2.3. FTIR Analysis
2.4. Scanning Electron Microscopy and EDX Analysis
2.5. Raman Spectroscopy
2.6. Photocatalytic Analysis
2.7. Screening of Antibacterial Activity
2.7.1. Antimicrobial Susceptibility Test
2.7.2. Antifungal Activity
Fungi Tested
3. Experimental Methods
3.1. Characterisation Studies
3.2. Photocatalytic Dye Degradation Test
4. Conclusions
Author Contributions
Funding
Data Availability Statement
Acknowledgments
Conflicts of Interest
References
- Magdalane, C.M.; Priyadharsini, G.M.A.; Kaviyarasu, K.; Jothi, A.I.; Simiyon, G.G. Synthesis and characterization of TiO2 doped cobalt ferrite nanoparticles via microwave method: Investigation of photocatalytic performance of Congo red degradation dye. Surf. Interfaces 2021, 25, 101296. [Google Scholar] [CrossRef]
- Lin, J.; Song, T.; Liu, Z.; Yang, D.; Xiang, R.; Hua, W.; Wan, H. Effects of biodegradable biomedical porous MnO2 nanoparticles on blood components and functions. Colloids Surf. B Biointerfaces 2022, 217, 112667. [Google Scholar] [CrossRef] [PubMed]
- Hosseinzadeh, M.; Mozaffari, S.A.; Ebrahimi, F. Porous 3D-graphene functionalized with MnO2 nanospheres and NiO nanoparticles as highly efficient electrodes for asymmetric capacitive deionization: Evaluation by impedance-derived capacitance spectroscopy. Electrochim. Acta 2022, 427, 140844. [Google Scholar] [CrossRef]
- Song, X.; Chen, X.; Liang, Z.; Xu, D.; Liang, Y. Colorimetric determination of Hg(II) ions based on core/shell Au@MnO2 nanoparticles with oxidase-like activity. J. Mol. Struct. 2022, 1263, 133189. [Google Scholar] [CrossRef]
- Renuka, R.; Devi, K.R.; Sivakami, M.; Thilagavathi, T.; Uthrakumar, R.; Kaviyarasu, K. Biosynthesis of silver nano particles using phyllanthus emblica fruit extract for antimicrobial application. Biocatal. Agric. Biotechnol. 2020, 24, 101567. [Google Scholar] [CrossRef]
- Cui, Y.; Yang, K.; Lyu, Y.; Liu, P.; Zhang, Q.; Zhang, B. Hollow nitrogen-doped carbon nanofibers filled with MnO2 nanoparticles/nanosheets as high-performance microwave absorbing materials. Carbon 2022, 196, 49–58. [Google Scholar] [CrossRef]
- Wang, H.; Liang, Z.; Liu, C.; Zhu, L.; Xu, Y.; Zhou, L.; Yan, B. Construction of K and Tb Co-doped MnO2 nanoparticles for enhanced oxidation and detoxication of organic dye waste. Chemosphere 2022, 297, 134104. [Google Scholar] [CrossRef]
- Yuan, M.; Luo, F.; Rao, Y.; Yu, J.; Wang, Z.; Li, H.; Chen, X. SWCNT-bridged laser-induced graphene fibers decorated with MnO2 nanoparticles for high-performance flexible micro-supercapacitors. Carbon 2021, 183, 128–137. [Google Scholar] [CrossRef]
- Lam, S.M.; Lim, C.L.; Sin, J.C.; Zeng, H.; Lin, H.; Li, H. Facile synthesis of MnO2/ZnO coated on cotton fabric for boosted antimicrobial, self-cleaning and photocatalytic activities under sunlight. Mater. Lett. 2021, 305, 130818. [Google Scholar] [CrossRef]
- Logambal, S.; Maheswari, C.; Chandrasekar, S.; Thilagavathi, T.; Inmozhi, C.; Panimalar, S.; Bassyouni, F.; Uthrakumar, R.; Gawwad, M.R.A.; Aljowaie, R.M.; et al. Synthesis and characterizations of CuO nanoparticles using Couroupita guianensis extract for and antimicrobial applications. J. King Saud Univ.-Sci. 2022, 34, 101910. [Google Scholar] [CrossRef]
- Vimuna, V.M.; Raj, B.B.; Sam, S.C.; Xavier, T.S. One-pot temperature-controlled hydrothermal synthesis of α-MnO2 nanoparticles decorated thermally reduced graphene oxide composite as high-performance flexible aqueous symmetric supercapacitors. Diam. Relat. Mater. 2021, 120, 108707. [Google Scholar] [CrossRef]
- Kumar, S.; Choudhary, R.B. Influence of MnO2 nanoparticles on the optical properties of polypyrrole matrix. Mater. Sci. Semicond. Process. 2022, 139, 106322. [Google Scholar] [CrossRef]
- Lian, Y.; Yuan, X.; Wang, Y.; Wei, L. Highly sensitive visual colorimetric sensor for xanthine oxidase detection by using MnO2-nanosheet-modified gold nanoparticles. Spectrochim. Acta Part A Mol. Biomol. Spectrosc. 2022, 276, 121219. [Google Scholar] [CrossRef] [PubMed]
- George, A.; Raj, D.M.A.; Venci, X.; Raj, A.D.; Irudayaraj, A.A.; Josephine, R.L.; Sundaram, S.J.; Al-Mohaimeed, A.M.; Al Farraj, D.A.; Chen, T.W.; et al. Photocatalytic effect of CuO nanoparticles flower-like 3D nanostructures under visible light irradiation with the degradation of methylene blue (MB) dye for environmental application. Environ. Res. 2022, 203, 111880. [Google Scholar] [CrossRef]
- Aadil, M.; Mahmood, M.; Warsi, M.F.; Alsafari, I.A.; Zulfiqar, S.; Shahid, M. Fabrication of MnO2 nanowires and their nanohybrid with flat conductive matrix for the treatment of industrial effluents. Flatchem 2021, 30, 100316. [Google Scholar] [CrossRef]
- Panimalar, S.; Logambal, S.; Thambidurai, R.; Inmozhi, C.; Uthrakumar, R.; Muthukumaran, A.; Rasheed, R.A.; Gatasheh, M.K.; Raja, A.; Kennedy, J.; et al. Effect of Ag doped MnO2 nanostructures suitable for wastewater treatment and other environmental pollutant applications. Environ. Res. 2022, 205, 112560. [Google Scholar] [CrossRef]
- Saini, A.K.; Sahoo, S.K. Fluorescent pH sensing and MnO2 nanosphere directed turn-on sensing of glutathione using pyridoxal 5′-phosphate modified polydopamine nanoparticles. Inorg. Chem. Commun. 2022, 142, 109677. [Google Scholar] [CrossRef]
- Mohan, V.; Marappan, G.; Chidambaram, D.; Rajendran, K.; Surya, V.J.; Venugopal, G.; Sivalingam, Y. Photo-enhanced acetone adsorption on δ-MnO2 nanoparticles: A step towards non-invasive detection of diabetes mellitus. Mater. Lett. 2022, 306, 130944. [Google Scholar] [CrossRef]
- Deng, Y.; Chen, Z.; Huang, J.; Yang, G.; Zhang, Q.; Liu, Z.; Cao, Y.; Peng, F. MnO2 nanoparticles supported on CNTs for cumene oxidation: Synergistic effect and kinetic modelling. Chem. Eng. J. 2022, 444, 136666. [Google Scholar] [CrossRef]
- Wang, L.; He, H.; Zhang, C.; Sun, L.; Liu, S.; Wang, S. Antimicrobial activity of silver loaded MnO2 nanomaterials with different crystal phases against Escherichia coli. J. Environ. Sci. 2016, 41, 112–120. [Google Scholar] [CrossRef]
- Panimalar, S.; Subash, M.; Chandrasekar, M.; Uthrakumar, R.; Inmozhi, C.; Al-Onazi, W.A.; Al-Mohaimeed, A.M.; Chen, T.W.; Kennedy, J.; Maaza, M.; et al. Reproducibility and long-term stability of Sn doped MnO2 nanostructures: Practical photocatalytic systems and wastewater treatment applications. Chemosphere 2022, 293, 133646. [Google Scholar] [CrossRef] [PubMed]
- Geetha, N.; Sivaranjani, S.; Ayeshamariam, A.; Siva Bharathy, M.; Nivetha, S.; Kaviyarasu, K.; Jayachandran, M. High performance photo-catalyst based on nanosized ZnO-TiO2 nanoplatelets for removal of RhB under visible light irradiation. J. Adv. Microsc. Res. 2018, 13, 12–19. [Google Scholar] [CrossRef]
- Wang, S.; Zheng, H.; Zhou, L.; Cheng, F.; Liu, Z.; Zhang, H.; Zhang, Q. Injectable redox and light responsive MnO2 hybrid hydrogel for simultaneous melanoma therapy and multidrug-resistant bacteria-infected wound healing. Biomaterials 2020, 260, 120314. [Google Scholar] [CrossRef] [PubMed]
- Alhaji, N.M.I.; Nathiya, D.; Kaviyarasu, K.; Meshram, M.; Ayeshamariam, A. A comparative study of structural and photocatalytic mechanism of AgGaO2 nanocomposites for equilibrium and kinetics evaluation of adsorption parameters. Surf. Interfaces 2019, 17, 100375. [Google Scholar] [CrossRef]
- Gogoi, N.; Babu, P.J.; Mahanta, C.; Bora, U. Green synthesis and characterization of silver nanoparticles using alcoholic flower extract of Nyctanthesarbortristis and in vitro investigation of their antibacterial and cytotoxic activities. Mater. Sci. Eng. 2015, 46, 463–469. [Google Scholar] [CrossRef] [PubMed]
- Liu, S.; Ma, J.; Wang, S.; Chen, S.; Wang, B.; Li, J. nanoparticles incorporated Chitosan/calcium pyrophosphate hybrid micro flowers for antibacterial applications. Mater. Lett. 2019, 255, 126570. [Google Scholar] [CrossRef]
- Wu, W.; Wu, Z.; Yu, T.; Jiang, C.; Kim, W.-S. Recent progress on magnetic iron oxide nanoparticles: Synthesis, surface functional strategies and biomedical applications. Sci. Technol. Adv. Mater. 2015, 16, 023501. [Google Scholar] [CrossRef]
- George, A.; Raj, A.D.; Irudayaraj, A.A.; Josephine, R.L.; Venci, X.; Sundaram, S.J.; Rajakrishnan, R.; Kuppusamy, P.; Kaviyarasu, K. Regeneration study of MB in recycling runs over nickel vanadium oxide by solvent extraction for photocatalytic performance for wastewater treatments. Environ. Res. 2022, 211, 112970. [Google Scholar] [CrossRef]
- Maddila, S.N.; Maddila, S.; Bhaskaruni, S.V.; Kerru, N.; Jonnalagadda, S.B. MnO2 on hydroxyapatite: A green heterogeneous catalyst and synthesis of pyran-carboxamide derivatives. Inorg. Chem. Commun. 2020, 112, 107706. [Google Scholar] [CrossRef]
- Perumal, V.; Inmozhi, C.; Uthrakumar, R.; Robert, R.; Chandrasekar, M.; Mohamed, S.B.; Honey, S.; Raja, A.; Al-Mekhlafi, F.A.; Kaviyarasu, K. Enhancing the photocatalytic performance of surface—Treated SnO2 hierarchical nanorods against methylene blue dye under solar irradiation and biological degradation. Environ. Res. 2022, 209, 112821. [Google Scholar] [CrossRef]
- Patra, T.; Mohanty, A.; Singh, L.; Muduli, S.; Parhi, P.K.; Sahoo, T.R. Effect of calcination temperature on morphology and phase transformation of MnO2 nanoparticles: A step towards green synthesis for reactive dye adsorption. Chemosphere 2022, 288, 132472. [Google Scholar] [CrossRef]
- Qu, Y.; Zheng, X.; Ma, K.; He, W.; Wang, S.; Zhang, P. Facile coating of MnO2 nanoparticles onto polymer fibers via friction-heating adhesion for efficient formaldehyde removal. Chem. Eng. J. 2022, 430, 132954. [Google Scholar] [CrossRef]
- Kouotou, P.M.; Vieker, H.; Tian, Z.Y.; Ngamou, P.H.T.; El Kasmi, A.; Beyer, A.; Gölzhäuser, A.; Kohse-Höinghaus, K. Structure–activity relation of spinel-type Co–Fe oxides for low-temperature CO oxidation. Catal. Sci. Technol. 2014, 4, 3359–3367. [Google Scholar] [CrossRef]
- Al-Thubaiti, K.S.; Khan, Z.; Al-Thabaiti, S.A. Effects of CTAB and SDS on the nucleation and growth of MnO2 and Ag-doped MnO2 nanoparticles formation. J. Mol. Liq. 2022, 355, 118910. [Google Scholar] [CrossRef]
- Shannon, R.D. Revised Effective Ionic Radi and systematic studies of interatomic Distance in Halides and chaleogenides. Acta Crystallogr. 1976, 32, 751–767. [Google Scholar] [CrossRef]
- Panimalar, S.; Uthrakumar, R.; Selvi, E.T.; Gomathy, P.; Inmozhi, C.; Kaviyarasu, K.; Kennedy, J. Studies of MnO2/g-C3N4 hetrostructure efficient of visible light photocatalyst for pollutants degradation by sol-gel technique. Surf. Interfaces 2020, 20, 100512. [Google Scholar] [CrossRef]
- Dong, X.; Wang, X.; Wang, J.; Song, H.; Li, X.; Wang, L.; Chan-Park, M.; Li, C.M.; Chen, P. Synthesis of a MnO2–graphene foam hybrid with controlled MnO2 particle shape and its use as a supercapacitor electrode. Carbon 2012, 50, 4865–4870. [Google Scholar] [CrossRef]
- Manjula, N.; Kaviyarasu, K.; Ayeshamariam, A.; Selvan, G.; Diallo, A.; Ramalingam, G.; Mohamed, S.B.; Letsholathebe, D.; Jayachandran, M. Structural, morphological and methanol sensing properties of jet nebulizer spray pyrolysis effect of TiO2 doped SnO2 thin film for removal of heavy metal ions. J. Nanoelectron. Optoelectron. 2018, 13, 1543–1551. [Google Scholar] [CrossRef]
- Mollaei, Z.; Kermani, F.; Moosavi, F.; Kargozar, S.; Khakhi, J.V.; Mollazadeh, S. In silico study and experimental evaluation of the solution combustion synthesized manganese oxide (MnO2) nanoparticles. Ceram. Int. 2022, 48, 1659–1672. [Google Scholar] [CrossRef]
- Xu, R.; Wang, Z.; Gao, L.; Wang, S.; Zhao, J. Effective design of MnO2 nanoparticles embedded in laser-induced graphene as shape-controllable electrodes for flexible planar micro supercapacitors. Appl. Surf. Sci. 2022, 571, 151385. [Google Scholar] [CrossRef]
- Cao, M.; Zhuang, Z.; Liu, Y.; Zhang, Z.; Xuan, J.; Zhang, Q.; Wang, W. Peptide-mediated green synthesis of the MnO2@ZIF-8 core–shell nanoparticles for efficient removal of pollutant dyes from wastewater via a synergistic process. J. Colloid Interface Sci. 2022, 608, 2779–2790. [Google Scholar] [CrossRef]
- Arularasu, M.V.; Anbarasu, M.; Poovaragan, S.; Sundaram, R.; Kanimozhi, K.; Magdalane, C.M.; Kaviyarasu, K.; Thema, F.T.; Letsholathebe, D.; Mola, G.T.; et al. Structural, optical, morphological, and microbial studies on SnO2 nanoparticles prepared by co-precipitation method. J. Nanosci. Nanotechnol. 2018, 18, 3511–3517. [Google Scholar] [CrossRef] [PubMed]
- Ding, D.; Zhou, Y.; He, T.; Rong, S. Facet selectively exposed α-MnO2 for complete photocatalytic oxidation of carcinogenic HCHO at ambient temperature. Chem. Eng. J. 2022, 431, 133737. [Google Scholar] [CrossRef]
- Panimalar, S.; Chandrasekar, M.; Logambal, S.; Uthrakumar, R.; Inmozhi, C. Europium-doped MnO2 nanostructures for controlling optical properties and visible light photocatalytic activity. Mater. Today Proc. 2022, 56, 3394–3401. [Google Scholar] [CrossRef]
- Xie, C.; Xu, L.; Xia, Y.; Gang, R.; Ye, Q.; Koppala, S. Evaluation of visible photocatalytic performance of microwave hydrothermal synthesis of MnO2/TiO2 core-shell structures and gaseous mercury removal. Microporous Mesoporous Mater. 2022, 334, 111788. [Google Scholar] [CrossRef]
- Chandrasekar, M.; Subash, M.; Perumal, V.; Panimalar, S.; Aravindan, S.; Uthrakumar, R.; Inmozhi, C.; Isaev, A.B.; Muniyasamy, S.; Raja, A.; et al. Specific charge separation of Sn doped MgO nanoparticles for photocatalytic activity under UV light irradiation. Sep. Purif. Technol. 2022, 294, 121189. [Google Scholar] [CrossRef]
- Khatri, M.; Gupta, A.; Gyawali, K.; Adhikari, A.; Koirala, A.R.; Parajuli, N. Photocatalytic degradation of dyes using synthesized δ-MnO2 nanostructures. Chem. Data Collect. 2022, 39, 100854. [Google Scholar] [CrossRef]
- Bahiraei, A.; Behin, J. Sonochemical immobilization of MnO2 nanoparticles on NaP-zeolite for enhanced Hg (II) adsorption from water. J. Environ. Chem. Eng. 2020, 8, 103790. [Google Scholar] [CrossRef]
- Perumal, V.; Sabarinathan, A.; Chandrasekar, M.; Subash, M.; Inmozhi, C.; Uthrakumar, R.; Isaev, A.B.; Raja, A.; Elshikh, M.S.; Almutairi, S.M.; et al. Hierarchical nanorods of graphene oxide decorated SnO2 with high photocatalytic performance for energy conversion applications. Fuel 2022, 324, 124599. [Google Scholar] [CrossRef]
- Shoba, A.; Kavitha, B.; Aswathaman, H.; Ganesan, H.; Kumar, N.S. Synthesis, characterization and electrochemical sensors application of MnO2 nanoparticles. Mater. Today Proc. 2022, 48, 521–526. [Google Scholar] [CrossRef]
- Yu, W.; Liu, T.; Cao, S.; Wang, C.; Chen, C. Constructing MnO2/single crystalline ZnO nanorod hybrids with enhanced photocatalytic and antibacterial activity. J. Solid-State Chem. 2016, 239, 131–138. [Google Scholar] [CrossRef]
- Rahmat, M.; Bhatti, H.; Rehman, A.; Chaudhry, H.; Yameen, M.; Iqbal, M.; Al-Mijalli, S.; Alwadai, N.; Fatima, M.; Abbas, M. Bionanocomposite of Au decorated MnO2 via in situ green synthesis route and antimicrobial activity evaluation. Arab. J. Chem. 2021, 14, 103415. [Google Scholar] [CrossRef]

| Organism’s | Control | Concentration (%) | |||
|---|---|---|---|---|---|
| Pure MnO2 | MnO2 doped with Ag | ||||
| 60 | 80 | 60 | 80 | ||
| Bacillus subtilis | 19 | 12 | 21 | 18 | 25 |
| Escherichia coli | 22 | 13 | 20 | 19 | 24 |
| Aspergillus niger | 20 | 14 | 16 | 17 | 20 |
| Candida albicans | 21 | 13 | 19 | 20 | 23 |
Disclaimer/Publisher’s Note: The statements, opinions and data contained in all publications are solely those of the individual author(s) and contributor(s) and not of MDPI and/or the editor(s). MDPI and/or the editor(s) disclaim responsibility for any injury to people or property resulting from any ideas, methods, instructions or products referred to in the content. |
© 2023 by the authors. Licensee MDPI, Basel, Switzerland. This article is an open access article distributed under the terms and conditions of the Creative Commons Attribution (CC BY) license (https://creativecommons.org/licenses/by/4.0/).
Share and Cite
Anguraj, G.; Ashok Kumar, R.; Inmozhi, C.; Uthrakumar, R.; Elshikh, M.S.; Almutairi, S.M.; Kaviyarasu, K. MnO2 Doped with Ag Nanoparticles and Their Applications in Antimicrobial and Photocatalytic Reactions. Catalysts 2023, 13, 397. https://doi.org/10.3390/catal13020397
Anguraj G, Ashok Kumar R, Inmozhi C, Uthrakumar R, Elshikh MS, Almutairi SM, Kaviyarasu K. MnO2 Doped with Ag Nanoparticles and Their Applications in Antimicrobial and Photocatalytic Reactions. Catalysts. 2023; 13(2):397. https://doi.org/10.3390/catal13020397
Chicago/Turabian StyleAnguraj, G., R. Ashok Kumar, C. Inmozhi, R. Uthrakumar, Mohamed S. Elshikh, Saeedah Musaed Almutairi, and K. Kaviyarasu. 2023. "MnO2 Doped with Ag Nanoparticles and Their Applications in Antimicrobial and Photocatalytic Reactions" Catalysts 13, no. 2: 397. https://doi.org/10.3390/catal13020397
APA StyleAnguraj, G., Ashok Kumar, R., Inmozhi, C., Uthrakumar, R., Elshikh, M. S., Almutairi, S. M., & Kaviyarasu, K. (2023). MnO2 Doped with Ag Nanoparticles and Their Applications in Antimicrobial and Photocatalytic Reactions. Catalysts, 13(2), 397. https://doi.org/10.3390/catal13020397

